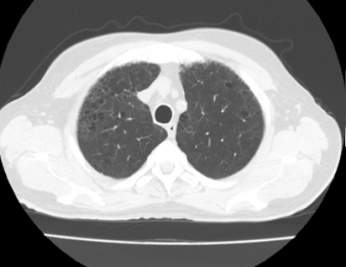
TC de t�rax

CARCINOMA ADENOESCAMOSO DE LARINGE: IMPACTO DEL FENOTIPO INUSUAL EN EL TRATAMIENTO DEFINITIVO. REPORTE DE CASO
CARCINOMA ADENOESCAMOSO DE LARINGE: IMPACTO DEL FENOTIPO INUSUAL EN EL TRATAMIENTO DEFINITIVO. REPORTE DE CASO
Revista Venezolana de Oncología, vol. 35, núm. 3, pp. 198-203, 2023
Sociedad Venezolana de Oncología

Esta obra está bajo una Licencia Creative Commons Atribución-NoComercial-CompartirIgual 4.0 Internacional.
Recepción: 25 Abril 2023
Aprobación: 10 Junio 2023
Resumen:
Los tumores laríngeos malignos incluyen una variedad de tipos histológicos con diferentes características biológicas, y por tanto requieren un enfoque terapéutico distinto dando lugar a una variedad en el pronóstico. CASO CLÍNICO: Caso de carcinoma adenoescamoso de laringe, de un paciente masculino de 57 años de edad quien desde julio 2016 presenta disfonía progresiva, acude a facultativo foráneo, quien lo evalúa y realiza nasofibrolaringoscopia, evidenciando tumor glótico, y refiere a este centro, donde es evaluado y se realiza laringoscopia directa más toma de biopsia, es estadificado como cT3N1M0 estadio III, se realiza en 2017 laringectomía total más disección cervical radical modificada bilateral, posteriormente se remite a servicio de radioterapia y oncología médica, recibe terapia adyuvante quimio-radioterapia concurrente, y se mantiene libre de enfermedad hasta la actualidad. DISCUSIÓN: Se trata de una neoplasia extremadamente rara, cuya caracterización histológica es distintiva, debido a la presencia de áreas mixtas de adenocarcinoma inequívoco y carcinoma de células escamosas. La cirugía y la radioterapia adyuvantes son necesarias debido a que el comportamiento biológico y el pronóstico de esta neoplasia se considera más agresivos que los del carcinoma de células escamosas convencional. No existe tratamiento estandarizado, se basa en la posibilidad de resección quirúrgica, cuya extensión dependerá de la infiltración tumoral a las estructuras adyacentes, seguido de radioterapia o quimio-radioterapia concurrente.
PALABRAS CLAVE: Cáncer, laringe, adenoescamoso, cabeza y cuello, cirugía, radioterapia, quimioterapia.
Palabras clave: Cáncer, laringe, adenoescamoso, cabeza y cuello, cirugía, radioterapia, quimioterapia.
Abstract: The malignant laryngeal tumors include a variety of histological types with different biological characteristics, and therefore require a different therapeutic approach and lead to a variety of prognosis. CLINICAL CASE: We present a case of adenosquamous carcinoma of the larynx, in a 57-year-old male patient who, since July 2016, has presented progressive dysphonia. He goes to a foreign doctor, who evaluates him and performs nasofibrolaryngoscopy, evidencing glottis tumor, and refers to this center. He is evaluated and direct laryngoscopy plus biopsy is performed, classified as cT3N1M0 stage III, total laryngectomy plus bilateral modified radical cervical dissection is performed in 2017, subsequently referred to the radiotherapy and medical oncology service, and he receives adjuvant concurrent chemo radiation therapy, the patient remains disease free to the date. DISCUSION: It is an extremely rare neoplasm, whose histological characterization is distinctive, due to the presence of mixed areas of unequivocal adenocarcinoma and the squamous cell carcinoma. The combined surgery and the additional adjuvant radiotherapy found to be necessary because the biological behavior and prognosis of this neoplasm considered more aggressive than those of conventional squamous cell carcinoma are. There is no standardized treatment; it based on the possibility of the surgical resection, whose extension resulted from tumor infiltration into the adjacent structures, followed by concurrent radiotherapy or chemo-radiation therapy.
Keywords: Cancer, larynx adenosquamous, head and neck, surgery, radiotherapy, chemotherapy.
INTRODUCCIÓN
El cáncer de laringe representa el 0,25 % del total de casos de cáncer a nivel mundial al año 2020 (1). El 90 % corresponde a carcinoma de células escamosas (2). La tasa de incidencia aumenta con la edad, siendo considerablemente mayor a partir de los 50 años, y predomina en hombres, con una relación de 7:1 respecto a las mujeres (1). En países como EE. UU, cada año se diagnostican aproximadamente 12 000 nuevos casos de cáncer laríngeo, con un resultado de 4 000 muertes al año (3). En Venezuela el cáncer de laringe ocupa el puesto número 18, en cuanto a incidencia y mortalidad estimada por Globocan 2020, con 1,3 % de casos nuevos, 1,5 % de mortalidad y con una tasa de supervivencia a 5 años de 7,16/100 000 habitantes. Los principales factores de riesgo son consumo de tabaco y alcohol (4), pero también se han descrito factores genéticos (5) y la infección por virus papiloma humano (6,7). La glotis representa la ubicación más frecuente (65 %), seguido de supraglotis (34 %) y subglotis (1 %) (8), sin embargo, existe literatura que utilizan la clasificación “transglótica” para referirse a carcinomas extensos que cruzan el ventrículo laríngeo y se extienden hacia el espacio paraglótico y la subglotis, en cuyo caso se dificulta definir su origen (4,9,10). Para su estadificación se utiliza la clasificación TNM de la American Joint Committee on Cancer (AJCC), que es específica para cada sitio en la laringe (11). Sin embargo, hay características comunes para todos los sitios, como, por ejemplo, la fijación de una cuerda vocal y la invasión del cartílago tiroides, que corresponden a un T3 y un T4 respectivamente (11). El cáncer de laringe suele diagnosticarse cuando ya es avanzado, lo que corresponde a los estadios III y IV (12). En relación al tratamiento, el cáncer de laringe en etapas avanzadas (T4) se realiza laringectomía total que puede asociarse a adyuvancia posoperatoria con radio-quimioterapia (12). De acuerdo con estudios extranjeros, esta patología presenta una supervivencia a cinco años de entre 73 % y 92 % en etapas iniciales y de 50 % a 64 % en etapas tardías (4).
El carcinoma adenoescamoso laríngeo representa del 0,5 % al 1 % de los subtipos de carcinoma de células escamosas del órgano. Se han descrito menos de 100 casos en la literatura internacional (13). Es un tumor bifásico caracterizado por la proliferación maligna de los componentes escamoso y glandular. Su origen se debe a la diferenciación divergente de las células más basales del epitelio (14). La clínica es indiferenciable del carcinoma escamoso clásico laríngeo, debutando con disfonía, disnea y disfagia en tumores voluminosos. Es predominante en hombres entre la sexta y séptima décadas de vida. Es característica la diseminación regional y a distancia, llegando a 75 % y 25 % respectivamente (15). Su presentación infrecuente limita el establecimiento de protocolos de tratamiento estandarizados, sin embargo, dado el curso agresivo de la enfermedad se aconseja el tratamiento quirúrgico agresivo como pilar fundamental, seguido de tratamiento adyuvante, dado por radioterapia o quimio-radioterapia concurrente (16,17).
En Venezuela, no se cuenta con un registro actual de la incidencia de casos y ni reportes de este tipo histológico, atribuible a la infrecuente incidencia en general, refiriendo poca información a nivel mundial y en nuestro país, por lo cual se considera de importancia presentar este caso a la comunidad, su manejo inicial y definitivo.
CASO CLÍNICO
Masculino de 57 años de edad, hipertenso y diabético tipo 2 controlado, con hábito tabáquico acentuado, índice paquete año (IPA) de 32 paquetes/año, con hábito etílico frecuente sin llegar a la embriaguez, con antecedente familiar oncológico de padre fallecido por cáncer de laringe, hermano fallecido por cáncer de pulmón, quien refiere inicio de enfermedad actual en julio de 2016 presentando disfonía progresiva, por lo cual decide acudir a facultativo foráneo en septiembre de 2016, quien lo evalúa y realiza nasofibrolaringoscopia, evidenciando tumor glótico, y decide referir a este centro.
Paciente quien se evalúa en área de consulta, y se solicita tomografía computarizada (TC) de cuello y tórax (Figura 1 y 2), donde se observa obliteración parcial del lumen laríngeo, sin erosión de sus cartílagos, además ganglios linfáticos cervicales bilaterales menores de 1 cm, y a nivel torácico enfermedad bulosa extensa a predominio de lóbulos superiores, sin lesiones nodulares sugestivas de extensión secundaria. Se decide realizar laringoscopia directa más toma de biopsia, en área quirúrgica, donde se evidencia como hallazgos, una tumoración exofítica, friable, que ocupa la cuerda vocal izquierda con infiltración a ambos repliegues aritenoepiglóticos.

Figura 1.
TC de cuello
Figura 2.
TC de tórax
Posteriormente se recibe resultado de biopsia que reporta una neoplasia maligna epitelial con predominio escamoso (80 %), junto a islotes de diferenciación glandular incompleta, infiltrando el estroma (Figura 3y 4, flecha y óvalos azules).
Paciente a quien se define diagnóstico de carcinoma adenoescamoso de laringe cT3N1M0 estadio III y se decide realizar laringectomía total más disección cervical radical modificada bilateral, obteniendo pieza quirúrgica, evaluada por anatomía patológica, concordante con diagnóstico histopatológico inicial, que reporta márgenes negativos y dieciséis ganglios linfáticos en total, libres de neoplasia (Figura 5), por lo cual se corrige diagnóstico definitivo: carcinoma adenoescamoso de laringe pT3N0M0 estadio III

Figura 3
Especímenes de laringoscopia directa (H-E)

Figura 4
Espécimen de laringectomía total (H-E)
l caso es discutido en reunión del servicio de cabeza y cuello y se decide referir al servicio de radioterapia, el paciente cumple radioterapia adyuvante, 6 120 cGy, actualmente se encuentra libre de enfermedad.
DISCUSIÓN
El diagnóstico de cáncer laríngeo de histología inusual se ha convertido en un desafío para el especialista. Según los casos reportados de carcinomas de laringe, la disfonía es el primer signo en manifestarse, según Pradenas y col. (18) al igual que Sotomayo y col. (5), donde encontraron en su estudio retrospectivo, que la disfonía está presente en más del 90 % de los casos. En nuestro medio, el retraso en la consulta representa el mayor problema de estos pacientes, atribuyéndose al rechazo del paciente para acudir a la misma, al desconocimiento de la población o incluso de los profesionales de atención primaria de salud, para identificar la disfonía crónica como un síntoma que, pudiese ser causado por un cáncer laríngeo, especialmente en pacientes con factores de riesgo como el consumo de tabaco y alcohol (5).
Uno de los factores de riesgos importantes y presente en este caso, es el hábito tabáquico en correlación con el consumo de OH, la relación entre presencia de hábito tabáquico y aparición de tumores de histología inhabitual no está descrita en la literatura como significativa, sin embargo, es un hábito frecuente en pacientes con carcinoma de laringe, en general, como en nuestro caso (19).
En relación a la ubicación del tumor, aquellos que comprometen en forma exclusiva la subglotis tienen una tendencia a ser de histología inusual. Contreras y col., describen 43 pacientes portadores de carcinoma escamoso de laringe, ninguno tenía lesión solo en la subglotis (4). De los cinco pacientes que se reportan en esta publicación, dos son de localización subglóticos. Un caso de condrosarcoma y carcinoma adenoideo-quístico, respectivamente. Para ambos tumores, la localización subglótica es la más frecuentemente descrita(4 ,8) (Error 4: La referencia , debe estar ligada) (Error 5: El tipo de referencia , es un elemento obligatorio) (Error 6: No existe una URL relacionada).
Por subsiguiente, podemos considerar, que los carcinomas adenoescamosos, siendo de histología muy rara, en cuanto a su incidencia, debe sospecharse con base estadística en pacientes menores de 60 años y de localización subglótica. Además, se debe considerar en pacientes de sexo femenino, no fumadoras y cuando el diagnóstico histológico requiera de más de una toma de muestra.
En el tratamiento y manejo de estos pacientes, la literatura describe, las principales modalidades de que son: la radioterapia y la quimio-radiación concurrente, en un estudio realizado por Sotomayor y col. (4) del total de su población, el tratamiento adyuvante, se basó en la radioterapia o radio-quimioterapia en 63,79 % de los 174 pacientes que tuvieron tratamiento con intención curativa, así como laringectomía total en 28,73 %. Se reportó una ausencia de tratamiento adyuvante en 30,6 % de los pacientes sometidos a laringectomía total, lo que puede vincularse a la ausencia de un comité oncológico durante los primeros años estudiados en dicha investigación. En esta línea, se ha descrito que aproximadamente un 60 % de los pacientes en T3 y T4 que reciben tratamiento quirúrgico deberán ser sometidos a radioterapia adyuvante (16,20), y esta cifra debe alcanzar el 100 % en los pacientes portadores de un carcinoma T4. Aunque en este estudio no se evidenció una diferencia significativa en las curvas de supervivencia entre los pacientes que recibieron adyuvancia posoperatoria antes y después de 8 semanas, esto podría asociarse al bajo tamaño del subgrupo que recibió adyuvancia (33 pacientes). Si reportan la supervivencia global de los pacientes en estadios precoces de 86,6 % a 2 años y 77,4 % a 5 años, así como 45,2 % a 2 años y 33 % a 5 años para los estadios avanzados (4). Esto concuerda con otros estudios realizados en EE. UU por Wolf y col. (17).
Concluimos en:
- El carcinoma adenoescamoso laríngeo es infrecuente y su diagnóstico es fundamentalmente patológico, ya que la clínica, estudios de imágenes y macroscópico no difiere del resto de histologías del carcinoma de laringe.
- No existe tratamiento estandarizado; sin embargo, la tendencia terapéutica se basa en el tratamiento quirúrgico, principalmente, cuya extensión dependerá de la infiltración tumoral a las estructuras adyacentes, seguido de radioterapia o quimio-radioterapia concurrente.
REFERENCIAS
1. World Health Organization (WHO). GLOBOCAN, International Agency for Research on Cancer (IARC), 2020. Disponible en: URL: https://www.uicc.org/news/globocan-2020-new-global-cancer-data
2. Luers J, Sircar K, Drebber U, Beutner D. The impact of laryngeal dysplasia on the development of laryngeal squamous cell carcinoma. Eur Arch Otorhinolaryngol. 2014;271(3):539-545.
3. Cardemil F, Ortega G, Cabezas L. Importancia de la epidemiología en cáncer laríngeo: Incidencia y mortalidad por carcinoma escamoso de laringe. Rev Otorrinolaringol Cir Cabeza Cuello. 2017;77(1):107-112.
4. Sotomayor JD, Cabezas CL, Fernández LA, Schuller FM, Torrejón W, Papuzinski AC. Supervivencia de carcinoma escamoso de laringe en Hospital Carlos Van Buren. Rev. Otorrinolaringol Cir Cabeza Cuello. 2020;80(3):286-294.
5. Conway DI, Hashibe M, Boffetta P, INHANCE consortium, Wunsch-Filho V, Muscat J, et al. Enhancing epidemiologic research on head and neck cancer: INHANCE - The international head and neck cancer epidemiology consortium. Oral Oncol. 2009;45(9):743-746.
6. IARC Working Group on the evaluation of carcinogenic risks to humans. Human papillomaviruses. IARC Monogr Eval Carcinog Risks Hum. 2007;90:1-636.
7. Mehanna H, Jones T, Gregoire V, Ang K. Oropharyngeal carcinoma related to human papillomavirus. BMJ. 2010;340:c1439.
8. Nocioni R, Molteni G, Mattiuzi C, Lippi G. Updates on larynx cancer epidemiology. Chin J Cancer Res. 2020;32(1):18-25.
9. Orellana M, Chuang A, Fulle A, Fernández R, Loyola F, Imarai C. Cáncer de laringe: serie de casos en 6 años en el Complejo Asistencial Doctor Sótero del Río. Rev Otorrinolaringol Cir Cabeza Cuello. 2017;77(1):35-43.
10. Contreras P, Muñoz D, Contreras J, Rahal M. Momento de inicio de radioterapia posoperatoria como factor pronóstico en pacientes con cáncer de laringe avanzado. Rev Otorrinolaringol Cir Cabeza Cuello. 2018;78:406-412.
11. Amin M, Edge S, Greene F, Compton C, Gershenwald J, Brookland R, et al. AJCC Cancer Staging Manual. 8. edición. Nueva York: Springer International Publishing; 2017.
12. Steuer C, El-Deiry M, Parks J, Higgins K, Saba NF. An Update on larynx cancer. CA Cancer J Clin. 2017;67(1):31-50. https://doi.org/10.3322/ caac.21386.
13. Dubal PM, Unsal AA, Echanique KA, Vazquez A, Reder LS, Baredes S, et al. Laryngeal adenosquamous carcinoma: A population-based perspective. Laryngoscope. 2016;126:858-863.
14. Gale N, Zidar N, Cardesa A, Nadal A. Benign and potentially malignant lesions of the squamous epithelium and squamous cell carcinoma. En: Cardesa A, Slootweg PJ, Gale, Franchi A, editores. Pathology of the head and neck. Berlin: Springer;2016. p.1-48.
15. Ferlay J, Soerjomataram I, Dikshit R, Eser S, Mathers C, Rebelo M, et al. F. Cancer incidence and mortality worldwide: sources, methods and major patterns in GLOBOCAN 2012. Int J Cancer. 2015;136(5):E359-E386. doi: 10.1002/ijc.29210
16. Graboyes E, Zhan K, Garrett-Mayer E, Lentsch E, Sharma A, Day T. Effect of Postoperative radiotherapy on survival for surgically managed pT3N0 and pT4aN0 laryngeal cancer: Analysis of the National Cancer Data Base. Cancer. 2017;123:2248-2257. https://doi.org/10.1002/cncr.30586.
17. Wolf GT, Bellile E, Eisbruch A, Urba S, Bradford CR, Peterson L, et al. Survival rates using individualized bioselection treatment methods in patients with advanced laryngeal cancer. JAMA Otolaryngol Head Neck Surg. 2017;143:355-366.
18. Pradenas M, Vallejos M, Rahal M, Cisternas A. Cáncer de laringe e hipofaringe. Experiencia del Hospital Barros Luco Trudeau 1990-2001. Rev Otorrinolaringol Cir Cabeza Cuello. 2004;64:13-20.
19. Passon P, Tessitori G, Lombardo M, Callea S, Poli, P. Long-surviving case of adenosquamous carcinoma of the larynx: Case report and review of literature. Acta Otorhinolaryngologica Italica. 2005;25(5):301-303.
20. Skóra T, Nowak-Sadzikowska J, Mucha-Malecka A, Szyszka-Charewicz B, Jakubowicz J, Glinski B. Postoperative irradiation in patients with pT3-4N0 laryngeal cancer: Results and prognostic factors. Eur Arch Otorhinolaryngol. 2015;272(3):673-679.
Notas de autor
melainechirinos@gmail.com